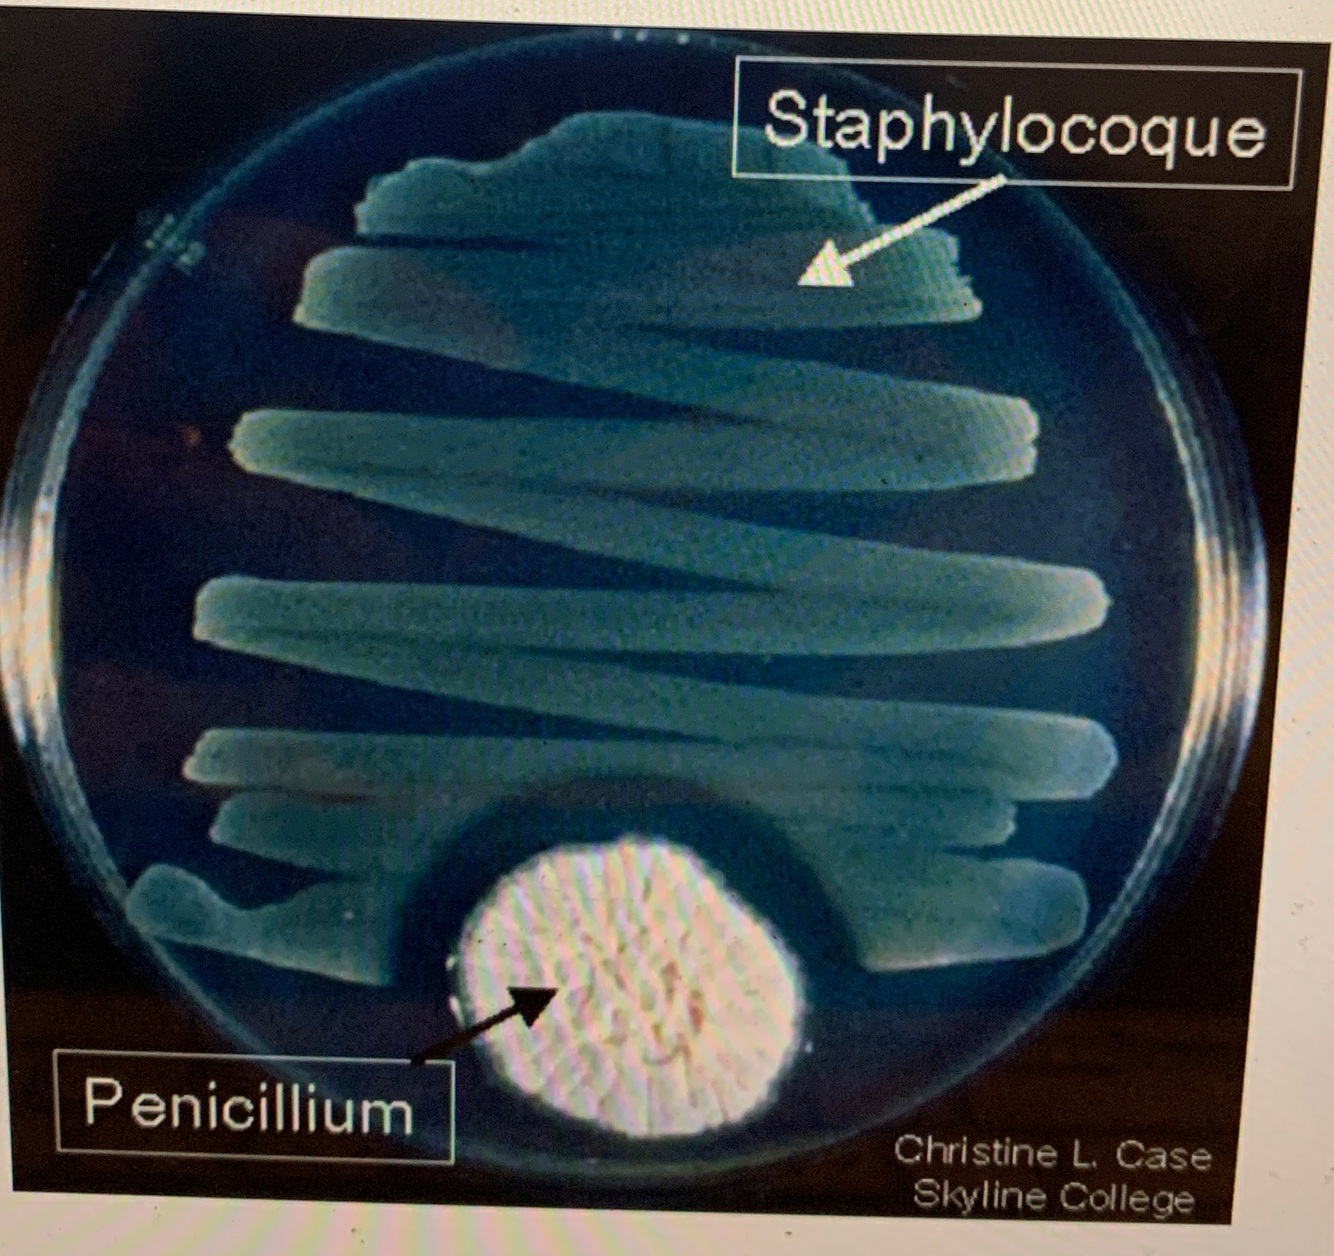

Métabolite primaire vs secondation
Primaire —> impliqué dans de nombreux réactions – débit élevée
Secondaire —> métabolite qui ne sert plus à des réactions (et qui d’habitude est excrété) – débit faible

Métabolites 2e sont quoi?
statiques
= déchets (excrétion), mais aussi:
= « produits »
—> un individu peut a priori très bien vivre sans ce « produit »
En règle générale, ces « produits » sont des toxines, colorants, odorants…
—> leur présence peut indiquer une bonne santé métabolique (ils « coutent cher » (en production))

métabolites secondaires servent à quoi?
à la communication –
compétitives ou mutualiste - souvent inter-espèces!
Ex. toxines de défense, colorants, odorants, aromates, etc comme avertissant et/ou attractants, ou « armes biologiques »
la synthèse de métabolites secondaires (évolution)
des variations d’enzymes déjà existants au niveau du métabolisme primaire ont évoluées (souvent par fusion/duplication de gènes).
• Il n’y a donc PAS de réelle révolution inventive – c’est plutôt un jeu avec des variations et combinaisons.
—> coevolution angiospermes (plantes à fleurs) avec insectes = un des moteurs de la diversification des métabolites secondaires (comme des VOCs, mais aussi des colorants) et leurs synthèses
Quantité de metabolites 2e
produites en petite quantité, et sont hiérarchisés après les métabolites centraux (primaires).
Par exemple, des bactéries en produisent plutôt en phase stationnaire.
Les points/composés de départ pour les voies métaboliques spécialisées/secondaires
des métabolites du métabolisme central

Classement des metabolites 2e
se ressemblent par leurs structures chimiques (et leurs voies de synthèse)
—> indique leur bioactivité pas leur fonction
groupes distincts, tels que alcaloïdes, terpénoïdes, composés phénoliques, etc.
Intérêt des metabolites 2e
• industrie pharmaceutique,
• la parfumerie
• l’industrie agro-alimentaire (aromates, colorants)
• médicaments
Métabolite 2e important des bacteries
antibiotiques
—> produits particulièrement lorsque la bactérie est en compétition avec d’autres microorganismes (bactéries, ou champignons versus bactéries)

2-azetidinone (noyau b-lactame)
Ex. Pénicilline (1er antibiotique)
- groupe chimique b-lactame
- Surtout contre bactéries à Gram+
- inhibition de la formation de la parois bactérienne
- se fixent aux enzymes de synthèse de la paroi (pseudosubstrat)
- produites par Pennicillium (champignon)

Plupart des antibiotiques font quoi?
Bactériostatiques
—> syst. immunitaire fait le reste du travail
pas bactéricides

Tetracyclines
- groupe chimique : polycétides
- condensation itérative de sous-unités acétyle ou malonyle par les polycétide synthases
- à spectre large contre bactéries Gram+ et Gram -
- inhibition de la traduction
- se fixent à la sous-unité 30S du ribosome
- produites par Streptomyces (bactérie Gram+)
- des dérivés semi-synthétiques existent

Macrolides
Ex. Erythromycine
- groupe chimique : polycétides, couplé par glucides
- contre bactéries Gram-
- spectre plus large que pénicilline aussi contre les intracellulaires
- application dans le cas d’allergie contre b-lactames
- inhibition de la traduction
- se fixent à la sous-unité 50S du ribosome
- produites par Streptomyces
Enzyme itérative
le produit est/devient le substrat
(plusieurs tours)
Ex . Synthèse de l’acide palmitique à partir du malonyl coa

Synthèse de composés de façon itérative
enzymes à multiples domaines comme NRPS (nonribosomal peptide synthetases) et PKS (polykétidesynthase) itératives (= PKS de type 1)
—> NRPS synthétisent des métabolites secondaires circulaires. S’ils sont synthétisés de façon strictement itérative, ils sont aussi symétriques.

Comment obtenir de la variation en utilisant des enzymes à multiples domaines comme NRPS (nonribosomal peptide synthetases)
chaine de production linéaire
au lieu de passer le substrat plusieurs fois par la même enzyme de façon itérative, on les enchaine plutôt, dans une chaine de production linéaire modulaire

la cyclosporine
PAS un antibiotique
métabolite secondaire de
champignon (Tolypocladium inflatum).
puissant inhibiteur de la réponse immune
—> immunosuppressant permet par exemple des transplantations.

Les macrolides et tétracyclines sont synthétisés par?
Des PKS modulaires (polykétidesynthase)
• système de chaine modulaire plutôt que itérative

Aminoglycosides/Aminosides
—> Streptomycine
- groupe chimique : 2 à 5 glucides aminés (base: D-glucose-6-phosphate)
- contre bactéries à Gram- et Mycobactérium tuberculosis
- inhibition de la traduction
- se fixent à la sous-unité 30S du ribosome
- produites par actinomycètes, p. ex. Streptomyces
- Effets secondaires –> antibiotique de réserve
aspects à considérer (antibiotiques )
1) la cible
-paroi, synthèse protéique (50S/30S), élongation ARN…
2) les spectres
- à spectre large ou à spectre étroit
3) Développement de résistance
- Pénétration dans les bactéries
- Pharmacocinétique dans les humains
- Effets secondaires
Antibiotique de réserve (last resort)
Vancomycine une glycopeptide

L’apparition de souches résistants est favorisé par:
- L’utilisation inadéquate d’antibiotiques (sous-dosage)
- L’utilisation très répandue d’antibiotiques, par exemple dans l’élevage du bétail
Souches résistantes caractéristiques
expriment souvent des « gènes de résistance »
—> plupart sont codées sur les plasmides
—> autres sur transposons
—> peuvent se répandre entre différentes espèces (implique souvent des plasmides)

gènes de résistance expriment des protéines qui permettent de :
- extraire l’antibiotique
- détruire l’antibiotique
- modifier la cible
de l’antibiotique








